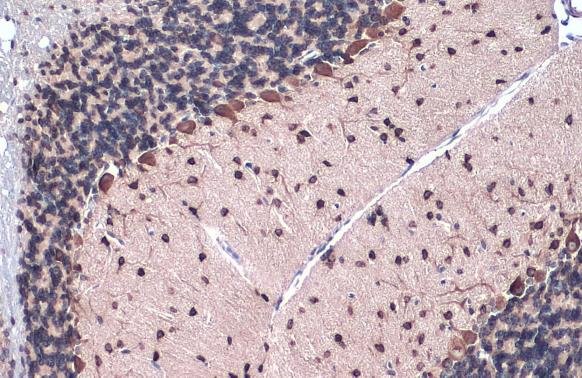

マイストア
変更
お店で受け取る
(送料無料)
配送する
納期目安:
2025.09.15 8:44頃のお届け予定です。
決済方法が、クレジット、代金引換の場合に限ります。その他の決済方法の場合はこちらをご確認ください。
※土・日・祝日の注文の場合や在庫状況によって、商品のお届けにお時間をいただく場合がございます。
【美品】ALBIT GFD-1 K056051 INTERNATIONAL BENDIX ABS MODULATOR VALVE, 4037420C1の詳細情報
K056051 INTERNATIONAL BENDIX ABS MODULATOR VALVE, 4037420C1。Amazon.com: Bapmic Front Left and Right Control Arm Kit。Anti-Gfap antibody (GTX128741) | GeneTex。アンプライクな素晴らしいディストーションペダルです気に入っていましたが、他に要るものがあるため、出品します箱、同梱物あり部屋弾きのみの美品です以下引用ICを使用せずに真空管の特性に近いトランジスタ(FET)で組み上げたギター・ベース兼用のディストーションです。Touch-free, programmable faucet for Patient Care。ゲインの可変範囲を広く取るためにハイゲインアンプと同様の回路を採用し、ソフトクランチからハードドライブまで幅広いゲインの調整が可能です。オールデイズ ロカビリー パーティー ギター 弦 看板 置物 LEDライトBOX。また、ローカットスイッチを採用しており、使用環境による不快な低域をカットすることが可能です。極厚5㎜オイルレザー使用 ギターストラップ ハンドメイド ブラウン。電源は一般的なDC9VからDC15Vまで対応しています。ロカビリー ギター ライブ ミュージック ロック 看板 置物 雑貨 ライトBOX。電源:DC9V-15V(センターマイナス)コントロール:Soft Crunch-Crunch-Drive(GAIN)・MASTER・TONEスイッチ:LOW・BYPASS端子:INPUT・OUTPUT・DC9V-15V外形寸法:70mm(W)×100mm(D)×50mm(H)重量:240g付属品:電池006P・取扱説明書・保証書
ベストセラーランキングです
近くの売り場の商品
カスタマーレビュー
オススメ度 4.2点
現在、1972件のレビューが投稿されています。